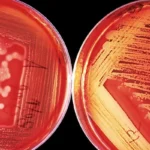
red bacteria 7

How Water Filters Affect Alkaline Levels
- Published:
- Updated: January 12, 2025
Summary
Water filtration systems can impact the alkalinity of water, influencing both its taste and its potential health benefits. This article explores how different filters affect alkaline levels and the broader implications for water quality.
- Reverse Osmosis Systems: These systems remove minerals that contribute to alkalinity, but post-filtration alkaline filters can restore essential minerals and balance the pH.
- Activated Carbon Filters: While excellent for removing contaminants like chlorine, these filters do not significantly alter alkalinity. They are often paired with mineral-enhancing filters to address pH balance.
- Ion Exchange Systems: Used for water softening, these systems may subtly increase alkalinity by replacing calcium and magnesium with sodium or potassium ions.
In the evolving landscape of residential water treatment, understanding how water filtration systems impact the alkaline levels of water is crucial. Alkalinity in water, a measure of its ability to neutralize acids, plays a significant role in water chemistry and consumption safety. As more households seek to optimize their water quality, the influence of filtration on alkalinity has become a focal point. This article explore how various water filters influence alkaline levels and the broader implications for water quality.
Understanding Alkalinity in Water
Alkalinity refers to the water’s capacity to resist changes in pH that would make the water more acidic. It is a critical component of water chemistry, acting as a buffer that helps maintain a stable pH level, which is essential for both environmental and human health. Primarily, alkaline water contains dissolved minerals such as calcium, magnesium, and bicarbonates, which contribute to its buffering capacity. These minerals not only influence the pH but also the taste and overall quality of the water.
The health implications of consuming alkaline water have been widely debated, with proponents suggesting that it offers health benefits like improved hydration and acid-neutralizing potential. Some studies indicate that alkaline water may help neutralize acid in the bloodstream, leading to increased oxygen levels, higher energy, and improved metabolism. However, skeptics argue that the body naturally regulates pH balance, making the benefits of alkaline water negligible. Despite differing opinions, the discussion underscores the importance of understanding water’s alkaline properties and their implications for health and wellness.
The Role of Alkaline Water Filters
Alkaline water filters are specifically designed to increase the pH level of water, making it more alkaline. These filters often work by adding minerals such as calcium, potassium, and magnesium back into the water after filtration. This process not only enhances the water’s taste but also its alkalinity, potentially offering the associated health benefits. The technology behind alkaline filters can vary, with some systems using ceramic or mineral cartridges to infuse water with essential minerals.
In addition to improving taste and potential health benefits, alkaline filters can also extend the life of household appliances by reducing scale buildup. The minerals added by these filters can help prevent the corrosive effects of overly acidic water, protecting pipes, kettles, and water heaters. While the primary goal of alkaline filters is to adjust pH levels, the added benefits of equipment longevity and improved water aesthetics make them a popular choice for many consumers seeking comprehensive water treatment solutions.
Water Filtration Systems and Alkaline Levels
Different types of water filtration systems have varied impacts on the alkalinity of water. Understanding these differences is key to selecting a system that meets specific water quality needs. Here’s how some common systems interact with alkaline levels:

Reverse Osmosis Systems
Reverse osmosis (RO) systems are popular for their ability to remove a wide range of contaminants. However, they also strip water of naturally occurring minerals, which can lower the water’s alkalinity. This mineral removal can lead to water with a flat taste and lower pH, which may not be ideal for those seeking the benefits of alkaline water. In areas where water is naturally soft or low in minerals, this could result in water with a pH lower than ideal for consumption.
To counteract this, some systems incorporate an alkaline filter stage post-RO to restore desirable mineral content and alkalinity. These post-filtration stages often reintroduce essential minerals, balancing the pH and improving the taste of the water. As a result, consumers can enjoy the purity of RO-treated water without sacrificing the benefits of alkaline minerals. This hybrid approach allows for the removal of unwanted contaminants while maintaining desirable water chemistry.
Activated Carbon Filters
Activated carbon filters are excellent at removing chlorine, volatile organic compounds, and other taste and odor issues from water. These filters work through adsorption, where contaminants adhere to the surface of the carbon material, effectively purifying the water. However, they have little effect on the water’s mineral content and thus do not significantly alter its alkalinity. As a result, they are often paired with other filtration methods if altering pH or mineral content is a concern.
For those interested in maintaining or increasing water alkalinity, activated carbon filters can be part of a multi-stage filtration system. By combining them with mineral-enhancing filters, users can address both contaminant removal and alkaline balance. This integrated approach allows for the customization of water treatment, catering to specific health and taste preferences.
Ion Exchange Systems
Ion exchange systems, commonly used for water softening, can impact alkalinity indirectly. By replacing calcium and magnesium ions with sodium or potassium ions, these systems may affect the overall mineral balance of the water. This process primarily targets hardness but can have secondary effects on pH levels. While they do not specifically target alkalinity, changes in ion composition can subtly influence water pH.
In some cases, the addition of sodium or potassium can lead to a slight increase in water alkalinity. However, the primary benefit of ion exchange systems remains their ability to soften water, making it gentler on skin and appliances. For those concerned with both water softness and alkalinity, it may be beneficial to use ion exchange systems in conjunction with other filtration methods that enhance or maintain desired pH levels.
The Importance of Residential Water Testing
For homeowners keen on understanding and managing their water quality, residential water testing is indispensable. Comprehensive testing provides insights into not only the presence of contaminants but also the mineral content and alkalinity of the water. This data is essential for diagnosing potential issues and ensuring that water treatment systems are effectively addressing specific needs. With accurate water quality information, homeowners can make informed decisions about the best filtration solutions for their homes.
Testing is also a proactive measure in safeguarding health and maintaining system efficiency. By regularly monitoring water quality, homeowners can detect changes in mineral content and pH levels, allowing for timely adjustments to their filtration systems. This ongoing assessment ensures that water remains safe for consumption and that filtration systems continue to operate at peak performance. As water quality can fluctuate due to environmental factors or changes in municipal supply, consistent testing is a vital component of responsible water management.
Practical Steps in Water Quality Management
- Conduct Initial Water Testing: Before installing a water filter, test your water to understand its current pH, mineral content, and contaminant levels. This initial assessment provides a baseline for evaluating the effectiveness of any subsequent treatment measures. It also helps identify any immediate concerns that need addressing.
- Choose the Right Filtration System: Based on your water test results, select a filtration system that addresses your specific needs, whether it’s contaminant removal, mineral enhancement, or pH adjustment. Consider systems that offer flexibility and can be tailored to your evolving water quality requirements. Consulting with water treatment professionals can also aid in selecting the most suitable system.
- Regular Maintenance and Monitoring: After installation, conduct regular water testing to monitor changes in water quality and ensure that the filtration system is performing optimally. Routine maintenance, such as replacing filters and checking system components, is crucial to sustaining performance. Staying vigilant about water quality ensures that you reap the long-term benefits of a well-maintained filtration system.
Conclusion
Understanding the interplay between water filtration systems and alkaline levels is essential for maintaining optimal water quality. Whether you are a homeowner seeking to improve your drinking water or an environmental science student aiming to deepen your understanding of water chemistry, recognizing how different systems affect alkalinity can guide better decision-making. This knowledge empowers individuals to tailor their water treatment strategies to their specific needs, ensuring both safety and satisfaction.
By embracing informed choices and regular testing, you can ensure that your water not only meets safety standards but also aligns with your personal preferences for mineral content and pH balance. As the field of water quality continues to evolve, staying informed about these dynamics remains crucial for both personal health and environmental stewardship. The commitment to understanding and managing water quality is not only beneficial for individual households but also contributes to broader efforts in sustainable water resource management.
Share this on social media: